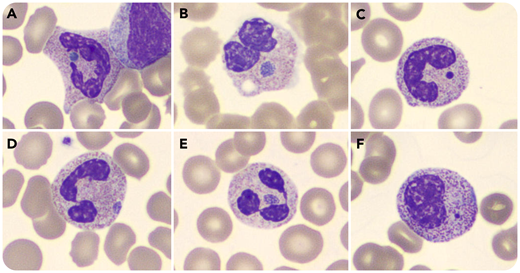
A 65-year-old woman underwent embolization of the left inferior epigastric artery. During this interventional radiology procedure, 2 detachable 2-mm coils were deployed surrounding gelfoam. Blood smear 36 hours later showed a round, blue neutrophilic inclusion likely representing engulfed gelfoam material (panel A; Wright stain). This inclusion was found in only a single neutrophil. For comparison, neutrophils containing morulae are shown from 3 other patients who tested positive by polymerase chain reaction for Ehrlichia ewingii and Ehrlichia canis (panel B; Wright stain) and Anaplasma phagocytophilum (panels D and E; Wright stain). In addition, panels C and F (Wright stain) contain detached nuclear remnants from other patients’ smears. The inclusion is a brighter blue in the patient who underwent gelfoam embolization. Her blood smear did not show Döhle bodies. Because she had been hospitalized for just over 3 months with complications from COVID-19, a tick bite was extremely unlikely. Furthermore, her blood smear did not show atypical lymphocytosis, and she was afebrile, in contrast to the other patients who had ehrlichiosis and anaplasmosis. Images are from Cellavision DM96 software which scans oil images of cells on blood smears (magnification for all panels, ×100).

A 65-year-old woman underwent embolization of the left inferior epigastric artery. During this interventional radiology procedure, 2 detachable 2-mm coils were deployed surrounding gelfoam. Blood smear 36 hours later showed a round, blue neutrophilic inclusion likely representing engulfed gelfoam material (panel A; Wright stain). This inclusion was found in only a single neutrophil. For comparison, neutrophils containing morulae are shown from 3 other patients who tested positive by polymerase chain reaction for Ehrlichia ewingii and Ehrlichia canis (panel B; Wright stain) and Anaplasma phagocytophilum (panels D and E; Wright stain). In addition, panels C and F (Wright stain) contain detached nuclear remnants from other patients’ smears. The inclusion is a brighter blue in the patient who underwent gelfoam embolization. Her blood smear did not show Döhle bodies. Because she had been hospitalized for just over 3 months with complications from COVID-19, a tick bite was extremely unlikely. Furthermore, her blood smear did not show atypical lymphocytosis, and she was afebrile, in contrast to the other patients who had ehrlichiosis and anaplasmosis. Images are from Cellavision DM96 software which scans oil images of cells on blood smears (magnification for all panels, ×100).
Other types of neutrophilic inclusions include Döhle bodies (shown in panel F), death granules [Blood. 2014;123(5):614], and detached nuclear remnants [Blood. 2015;125(17):2729].
A 65-year-old woman underwent embolization of the left inferior epigastric artery. During this interventional radiology procedure, 2 detachable 2-mm coils were deployed surrounding gelfoam. Blood smear 36 hours later showed a round, blue neutrophilic inclusion likely representing engulfed gelfoam material (panel A; Wright stain). This inclusion was found in only a single neutrophil. For comparison, neutrophils containing morulae are shown from 3 other patients who tested positive by polymerase chain reaction for Ehrlichia ewingii and Ehrlichia canis (panel B; Wright stain) and Anaplasma phagocytophilum (panels D and E; Wright stain). In addition, panels C and F (Wright stain) contain detached nuclear remnants from other patients’ smears. The inclusion is a brighter blue in the patient who underwent gelfoam embolization. Her blood smear did not show Döhle bodies. Because she had been hospitalized for just over 3 months with complications from COVID-19, a tick bite was extremely unlikely. Furthermore, her blood smear did not show atypical lymphocytosis, and she was afebrile, in contrast to the other patients who had ehrlichiosis and anaplasmosis. Images are from Cellavision DM96 software which scans oil images of cells on blood smears (magnification for all panels, ×100).
Other types of neutrophilic inclusions include Döhle bodies (shown in panel F), death granules [Blood. 2014;123(5):614], and detached nuclear remnants [Blood. 2015;125(17):2729].
For additional images, visit the ASH Image Bank, a reference and teaching tool that is continually updated with new atlas and case study images. For more information, visit http://imagebank.hematology.org.
This feature is available to Subscribers Only
Sign In or Create an Account Close Modal